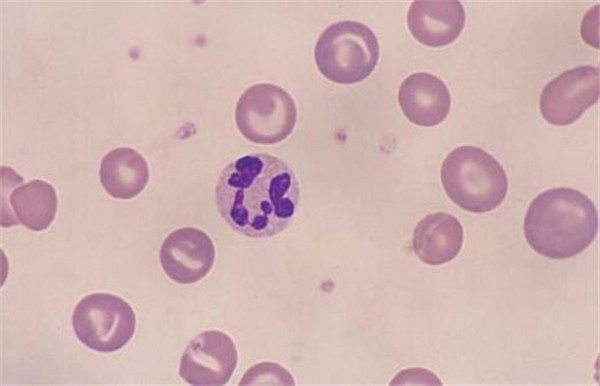

新闻动态

血常规检查是我们去医院看病时,最常做的和最基本的检查项目。检查血常规主要是为了医生能够判断疾病,以及排除贫血和是否存在血液疾病,并且对骨髓的造血功能有反应。常规血液检查后的检查结果清楚地列在清单上,不同的细胞结论显示不同的症状。但是通常没有医学基础的人是难以理解各项指标表达的含义,

那么血常规化验单怎么看呢?
1、白细胞系统
白细胞在血常规中显示“↑”或“↓”都不正常。它的总数是局限在正常范围内的,随年龄增长,正常值会逐渐降低。超过高值则疑有炎症存在,多为细菌感染,少于低值,可能是病毒感染,或药物作用。
2、血小板系统
血小板主要功能是防止出血,如低于正常值可能有出血倾向。血小板异常增多的人可能血栓的风险就会增加哦。
3、红细胞(RBC)
增高表示真性红细胞增多症,严重脱水,肺源性心脏病,先天性心脏病,高山地区的居民,严重烧伤,休克等。降低则可能为贫血,出血。

4、血红蛋白(Hb)
增高为真性红细胞增多症,严重脱水,肺源性心脏病,先天性心脏病,严重烧伤,休克等。降低为贫血,出血。
5、白细胞(WBC)
升高为各种细菌感染,炎症,严重烧伤。明显升高时应除外白血病。降低则表示白细胞减少症,脾功能亢进,造血功能障碍,放射线,药物,化学毒素等引起骨髓抑制,疟疾,伤寒,病毒感染,副伤寒。
6、中性粒细胞
增高为细菌感染,炎症;降低为病毒性感染。
7、嗜酸性粒细胞
增高为慢性粒细胞白血病及慢性溶血性贫血。
8、淋巴细胞
增高:百日咳为传染性单核细胞增多症,病毒感染,急性传染性淋巴细胞增多症,淋巴细胞性白血病;降低为免疫缺陷。
9、单核细胞
增高为结核,伤寒,疟疾,单核细胞性白血病。
10、血小板(PLT)
升高为原发性血小板增多症,真性红细胞增多症,慢性白血病,骨髓纤维化,症状性血小板增多症,感染,炎症,恶性肿瘤,缺铁性贫血,外伤,手术,出血,脾切除后的脾静脉血栓形成,运动后。降低为原发性血小板减少性紫癜,播散性红斑狼疮,药物过敏性血小板减少症,弥漫性血管内凝血,血小板破坏增多,血小板生成减少,再生障碍性贫血,骨髓造血机能障碍,药物引起的骨髓抑制,脾功能亢进。
检验报告单只是辅助临床医生做出最准确的治疗方案,最终决定诊断结果的还是临床医生总结各项检查报告,然后得出的最后结果,所以常规辅助检查不一定是绝对的。
 门诊时间
门诊时间  就诊指南
就诊指南 医保政策
医保政策 专家答疑
专家答疑